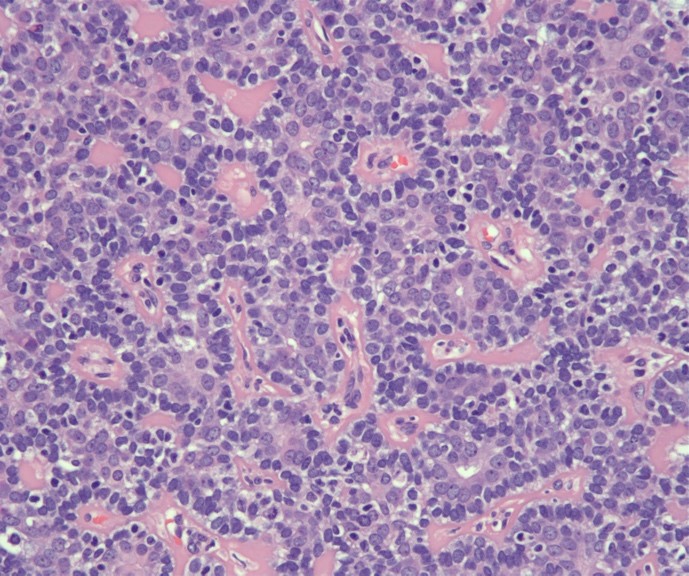

Table of Contents
Definition / general | Familial form (turban tumor syndrome, Brooke-Spiegler syndrome) | Spiradenocylindromas | Essential features | Terminology | ICD coding | Epidemiology | Sites | Pathophysiology | Etiology | Clinical features | Diagnosis | Radiology description | Prognostic factors | Case reports | Treatment | Clinical images | Gross description | Gross images | Microscopic (histologic) description | Microscopic (histologic) images | Virtual slides | Positive stains | Negative stains | Electron microscopy description | Molecular / cytogenetics description | Videos | Sample pathology report | Differential diagnosis | Practice question #1 | Practice answer #1 | Practice question #2 | Practice answer #2Cite this page: Dick M, Sharma P. Cylindroma. PathologyOutlines.com website. https://www.pathologyoutlines.com/topic/skintumornonmelanocyticeccrinecylindroma.html. Accessed July 25th, 2025.
Definition / general
- Benign tumor with debated origin from eccrine sweat glands or hair follicles
- Also called turban tumor, particularly when a large, multicentric scalp tumor
Familial form (turban tumor syndrome, Brooke-Spiegler syndrome)
- Autosomal dominant, multiple tumors of children / teenagers that may also involve trunk and extremities
- In association with spiradenoma, trichoepithelioma, milia or membranous variant of basal cell adenoma of salivary glands
- Due to mutations in CYLD gene at chromosome 16q12-13
- Rarely undergoes malignant transformation
Spiradenocylindromas
- Features of cylindroma and eccrine spiradenoma
- Benign
- Solitary or multiple
- Familial inheritance possible
Essential features
- Typically, solitary exophytic painless tumors (Lancet Oncol 2015;16:e460)
- Can develop multiple scalp lesions (turban tumor) (Int J Dermatol 2015;54:275)
- Multiple cylindromas associated with cylindromatosis gene (CYLD) mutations and Brooke-Spiegler syndrome; associated with earlier development (Lancet Oncol 2015;16:e460)
- Single lesions associated with MYB gene mutations (J Pathol 2016;239:197)
Terminology
- Cutaneous or dermal cylindromas
- Turban tumor
- Salivary cylindroma or cystic adenoid carcinoma
ICD coding
Epidemiology
- F > M (Dermatol Clin 2017;35:61)
- Middle aged and elderly women (Int J Dermatol 2015;54:275)
Sites
- Head, neck and scalp (Int J Dermatol 2015;54:275)
Pathophysiology
- Unclear pathophysiology, currently debated to be from eccrine, apocrine or follicular origin (Int J Dermatol 2015;54:275)
- MYB gene fuses with NFIB gene forming single sporadic tumors (J Pathol 2016;239:391)
- Germ line mutation on CYLD tumor suppressor gene on chromosome 16 leads to Brooke-Spiegler syndrome; autosomal dominant inheritance pattern (Head Neck Pathol 2016;10:125)
Etiology
- Currently unknown
Clinical features
- Solitary or multiple
- Primarily on head, neck and scalp
- Usually ages 40+ years
- F > M
- Rarely associated with similar tumors in major salivary glands
- Rare malignant transformation, local infiltration common (Lancet Oncol 2015;16:e460)
- Brooke-Spiegler syndrome associated with spiradenoma and trichoepithelioma formation (Dermatol Clin 2017;35:61)
Diagnosis
- Diagnosis based on biopsy histology (Dermatol Clin 2017;35:61)
- Consider genetic testing in patients with multiple cylindromas, spiradenomas or trichoepitheliomas and in patients with one of these solitary tumors and a first degree relative with any of these tumors (Dermatol Clin 2017;35:61)
Radiology description
- MRI imaging utilized with suspected malignant transformation of scalp tumors to detect intracranial invasion (Lancet Oncol 2015;16:e460)
Prognostic factors
- Rarely undergo malignant transformation (poorly established rate) with slightly higher risk in Brooke-Spiegler patients (Dermatol Pract Concept 2015;5:61)
- Salivary cylindromas are malignant with a poor 15 - 20 year survival (10 - 30%) (Curr Opin Otolaryngol Head Neck Surg 2017;25:147)
Case reports
- 38 year old man with numerous scalp cylindromas (Natl J Maxillofac Surg 2012;3:59)
- 58 year old man with facial cylindroma clinically mimicking basal cell carcinoma (Indian Dermatol Online J 2016;7:203)
- 73 year old woman with large pedunculated facial cylindroma (Open Access Maced J Med Sci 2018;6:1868)
- 75 year old man with cylindroma of the external ear (BMJ Case Rep 2016;2016:212035)
- 83 year old woman with Brooke-Spiegler syndrome presenting with malignant cylindromas (Dermatol Pract Concept 2015;5:61)
Treatment
- Treatment for cylindromas with CYLD mutations or tumors that are disfiguring or uncomfortable is with surgical excision (Dermatol Clin 2017;35:61)
- Mohs micrographic surgery may be necessary with recurrent tumors to confirm histologic clearance (Lancet Oncol 2015;16:e460)
- Radiotherapy is contraindicated as it can further induce DNA damage (Dermatol Clin 2017;35:61)
Clinical images
Gross description
- Pink-red dome shaped nodule with smooth surface
Microscopic (histologic) description
- Compact nests of basaloid cells that fit together like a jigsaw puzzle, surrounded by thick basement membrane (Dermatol Clin 2017;35:61)
- Cylindrical shape appreciated in cross section (Dermatol Clin 2017;35:61)
- 2 groups of cells:
- Undifferentiated peripheral palisading epithelial cells with small dark nuclei
- Centrally located increasingly differentiated ductal cells with large pale nuclei (Dermatol Clin 2017;35:61)
Microscopic (histologic) images
Positive stains
- CK7 (in central basaloid cells), CK8 (J Cutan Pathol 2009;36:190)
- EMA and CEA in ducts (Indian J Dermatol 2012;57:141)
- PAS highlights hyaline in basement membrane (Indian Dermatol Online J 2016;7:203)
Negative stains
Electron microscopy description
- Differentiation towards intradermal coiled duct region of eccrine sweat glands
- Compact small cells with dark nuclei on the periphery with larger cells containing light colored nuclei more centrally
- Ductal structures and thick hyaline bands present
Molecular / cytogenetics description
- Mutation in CYLD on chromosome 16 associated with multiple familial cylindromas
- MYB gene mutations associated with sporadic cylindromas
- Chromosome 16 CYLD mutation common
- CYLD codes for recessive cylindromatosis familial tumor suppressor gene a ubiquitin specific protease (Lancet Oncol 2015;16:e460)
- Majority of mutations are frameshift and result in truncated proteins (Hum Mutat 2009;30:1025)
- Mutations detected in 84% of reported Brooke-Spiegler patients and 88% in familial cylindromatosis (Hum Mutat 2009;30:1025)
- MYB activation (~12%) and MYB-NFIB fusion oncoproteins (~55%) present in sporadic tumors (J Pathol 2016;239:197)
Videos
Spiradenoma and cylindroma sweat gland tumor
Sample pathology report
- Forehead, excision:
- Benign adnexal tumor (see comment)
- Comment: There are cylindrically shaped nests of epithelial cells arranged in a jigsaw pattern surrounded by thick hyaline basement membrane. Immunohistochemically the tumor nests are express CK7 and 8 positivity, with EMA and CEA positivity in the accompanying duct structures. Tumor is CK20, GCDFP-15, ER and PR negative. These features support the diagnosis of cylindroma.
- Malignant transformation is unlikely. If multiple tumors are present, consider genetic testing for CYLD mutations as this is associated with Brooke-Spiegler.
Differential diagnosis
- Trichoepithelioma:
- Hair follicle tumor with basaloid cells in nests surrounded by dense fibrous stroma and spindle cells
- Mucin pools may be present within basaloid nests
- Lack of clefting distinguishes from basal cell carcinoma
- Spiradenoma:
- Can occur both separately and in combination with cylindromas
- Similar formation with peripheral small basaloid cells and larger paler cells centrally
- Lobulated tumor islands separated by thin fibrous tissue containing blood vessels
- Basal cell carcinoma:
- Lacks tight hyaline membrane separating epithelial islands
- Mucinous stroma with clefting artifact present
Practice question #1
- A 31 year old woman who was previously diagnosed with Brooke-Spiegler syndrome has developed three painless cutaneous tumors on her scalp. Tumor biopsy shows a jigsaw pattern of basaloid ovoid nests of tumor lobules located within the dermis, ductal structures and thick hyaline bands. Which of the following is true concerning this adnexal tumor?
- It can appear both separately and in conjunction with spiradenomas
- It most commonly appears on elderly males
- Malignant transformation occurs frequently
- Tumors are normally found on the lower extremities
Practice answer #1
A. It can appear both separately and in conjunction with spiradenomas
Comment Here
Reference: Cylindroma
Comment Here
Reference: Cylindroma
Practice question #2
- A 26 year old woman presents with multiple tumors on her scalp, neck and face. She otherwise feels well. Her mother has similar appearing tumors that have previously been diagnosed as cylindromas and spiradenomas. This is her first time seeking diagnosis as her tumors are disfiguring but generally painless. Testing for mutation in which gene should be recommended for this patient?
- CYLD
- MYB
- MYB-NFIB
- No genetic testing is recommended
Practice answer #2